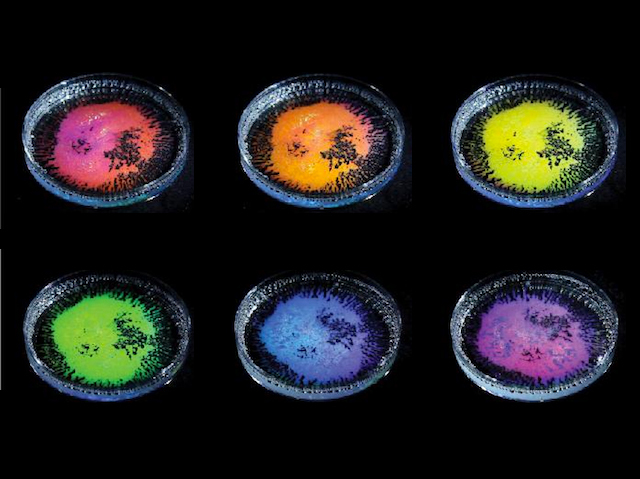

New technique for creating colour changes on demand could be applied to body function monitoring
26 March 2019
Light Angle
A burst of colour is a universal form of communication. We react to it – seeing danger, or maybe calm – it’s also a quick way to monitor changes during medical tests. Scientists and engineers are on the lookout for new ways to split, or refract, white light into its rainbow spectrum on demand. Here dishes of oil droplets display iridescence – illuminated with white light, they appear in different colours from different angles, creating a rainbow shimmer. The secret lies in obstructing the path of the light, a process known as structural colour – in this case two types of particles in the oil meet creating a hemisphere shape which refracts the light into coloured waves. It’s possible to manipulate these patterns, raising the possibility of using similar techniques to create iridescent paints, or perhaps new colorimetric sensors, worn of the body to keep tabs on bodily processes.
Written by
- Image from the Zarzar Lab, Penn State University
- The Pennsylvania State University, University Park, PA, USA
- Image copyright held by the original authors
- Research published in Nature, February 2019
Search The Archive
Submit An Image
Like us on Facebook
Follow on Twitter
Follow on Tumblr
Follow on Instagram
What is BPoD?
BPoD stands for Biomedical Picture of the Day. Managed by the MRC Laboratory of Medical Sciences until Jul 2023, it is now run independently by a dedicated team of scientists and writers. The website aims to engage everyone, young and old, in the wonders of biology, and its influence on medicine. The ever-growing archive of more than 4000 research images documents over a decade of progress. Explore the collection and see what you discover. Images are kindly provided for inclusion on this website through the generosity of scientists across the globe.
BPoD is also available in Catalan at www.bpod.cat with translations by the University of Valencia.








